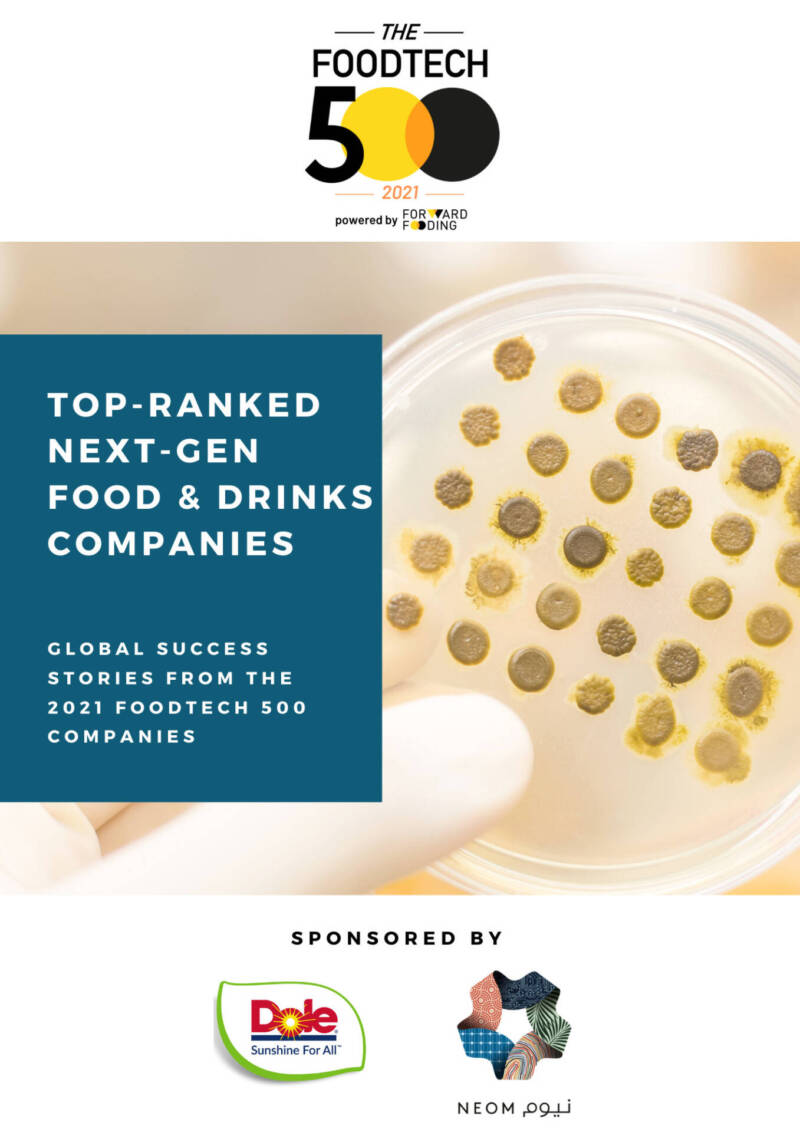

next gen tech initiatives pvt ltd
To enable the Clients to reach new. Wikki Stix Music Fun and How To.

Siriusdecisions Buying Process And How Other Activities Should Align To It Extract From Next Generation Inbound Marketing Persuasive Techniques Web Marketing
Please send your CV get in touch immediately.

. Once all the wax is melted drop 4-5 pieces of yarn into the wax. Located at the heart of Hyderabad Next Generation Technology India Private Limited started the staffing operations from the year 2016. How to make wikki stix.
In telecommunications IVR allows customers to interact with a companys. NextGenVision is leading Information Technology Services and BusinessKnowledge Process services provider delivering custom world class services which are business driven competitive and provide value to each of our customers. ISO 90012008 Certified Email Us.
We are a global team of highly experienced specialists in the business of mobile automotive networks connectivity testing. When you get a vaccine your immune system responds. Avoid in-market connectivity issues by finding and fixing bugs before launch.
Whether you are looking for a simple corporate site or a robust web application or a mobile application or someone who can partner in customer acquisition we are always. Recognizes the invading germ such as the virus or bacteria. September 30 at 906 AM.
Battery starter and alternator servicing using Bosch Auto Electrical Bench. Next Gen Tech Initiatives Pvt Ltd Plot A27 Rd no 10 MIDC W June 04 2022 Edit. Report this profile Articles by Rohit What are EVs Electric Vehicles By Rohit Godkar Jun 5 2020.
NextGen Infotech is a leading Business Technology consulting company in India. Our Innovative Solutions Includes Queue Management System IP Phones Door Phones Professional Call Center Headsets Point of Sale Hardware Software Customized KIOSK Customer feedback Social Wifi Drive-Thru. Solutions Provider Company for Hospitality Retail Industry in Pakistan.
University of Southern California. Next Gen Tech Initiatives Pvt Ltd. It is classified as Non-govt company and is registered at Registrar of Companies Cuttack.
Interactive voice response IVR is a technology that allows a computer to interact with humans through the use of voice and DTMF tones input via keypad. Join to Connect NextGen Tech Initiatives Pvt Ltd. Automated testing for your industry.
Nextgen Tech Initiatives Pvt Ltd - Service Provider of workable solution develop and prototype building service automotive service since 2013 in Thane Maharashtra. We are passionate about understanding an agency. 10 MIDC WAGLE INDUSTRIAL ESTATE THANE WEST THANE Thane MH 400604 IN -.
Legal Status of Firm. 10000000 and its paid up capital is Rs. 7 DIY CAR MAINTENANCE TIPS FOR EVERY CAR OWNER.
1 Ampere Scooter Dealers in Thane. Its authorized share capital is Rs. Effectiveness along with force of your employees management initiatives so maximising investment modish human being capital.
Next Generation Technologies NGT is a full-service technology company with products and services ranging from personal computing salesservice to multi-site WANLAN engineering project management IT strategic planning IT committee security and system integration. We take pride in helping to build and managing one of the worlds best open-access networks rolling out ultra-fast optical fibre broadband installing towers and maintaining them for smooth and fast to connect that will benefit the next generations. NextGen Technologies is Innovative IT.
Jojinextgentelein punitnextgentelein Phone. Plot A27 Rd No 10 MIDC Wagle Industrial Estate Thane Maharashtra 400604. Nextgen Tech Initiatives Private Limiteds Corporate Identification Number is CIN U74120MH2013PTC245470 and its registration number is 245470Its Email address is accountssynergyunitedin and its registered address is G-1 PLOT A-27 ROAD NO.
Next Gen Tech World Solutions Pvt. We have a state of the art workshop that conforms to international standards and caters to all the needs of your car. We help our global customer achieve speed and manage cost consistently.
NextGen Bosch Car Service a modern organized multi-brand one stop shop car service center located in the heart of Thane City spread over 14000 sq ft. I ncorporated in 2007 Next Generation Technology is committed to providing quality Staffing solutions for various organizations spread on almost all areas of the industry. Posts Atom Popular Posts.
Major engine gearbox suspension and electrical repairs backed by our strong technical team of skilled technicians and engineers. Next Generation Technology Industries Private Limited is a Private incorporated on 05 July 2007. NextGen Unicorn has an important role to play in shaping and supporting the clients success in various sectors.
We help our clients grow faster maximize profitability by leveraging Information Technology. Throughout its history NextGenVision has. Antibodies are proteins produced.
Company Recruiter HR Professional. Limited Company LtdPvtLtd Annual Turnover. Make A 3d Flower In A Po.
Job location is Noida. Director at NextGen Tech Initiatives Pvt Ltd Mumbai Maharashtra India 326 connections. AC servicing and gas re-filling.
Improve customer satisfaction and ship products with confidence. Next Gen Tech Initiatives Pvt Ltd. Including both legs of transactions customer and merchant agent we help you bridge the digital gap on financial inclusiondigital paymentstransit and more.
Bringing disruptive creativity and technology innovation to customers bridging gaps in existing services and targeted to the masses to reach the last mile. Deals in a variety of interactive response system services and solutions. Vaccines reduce risks of getting a disease by working with your bodys natural defenses to build protection.
NextGen Tech Initiatives Pvt Ltd. Wheel alignment balancing using our 6 CCD computerized alignment and balancing machine. Our 10 bay workshop is installed with modern Bosch and ATS-ELGI equipments.

Catalogue Nextgen Tech Initiatives Pvt Ltd In Wagle Industrial Estate Thane West Thane Justdial

Home Nextgen Bosch Car Service
Catalogue Nextgen Tech Initiatives Pvt Ltd In Wagle Industrial Estate Thane West Thane Justdial

Paint The Future Letspaintfuture Twitter

Exide Integra An Enhanced Power Backup Solution

Pdf Millennial Managers Exploring The Next Generation Of Talent

Innovative Wrapping Innovation Wraps Baling
The Foodtech 500 Forward Fooding Powering The Food Food Tech Revolution

Next Gen Customer Experience In Digital Banking 10 Must Have Features For 2022

Ai For Next Generation Computing Emerging Trends And Future Directions Sciencedirect

Vijay Kedia Recommends 4 Multibagger Stocks For 2019 Stock Recommendations Unwritten Recommended

Next Gen Adm The Future Of Application Services

Pdf Next Generation Innovation Policy And Grand Challenges

Catalogue Nextgen Tech Initiatives Pvt Ltd In Wagle Industrial Estate Thane West Thane Justdial

Pdf Surgical Data Science For Next Generation Interventions

Pdf Artificial Intelligence For Smart Renewable Energy Sector In Europe Smart Energy Infrastructures For Next Generation Smart Cities